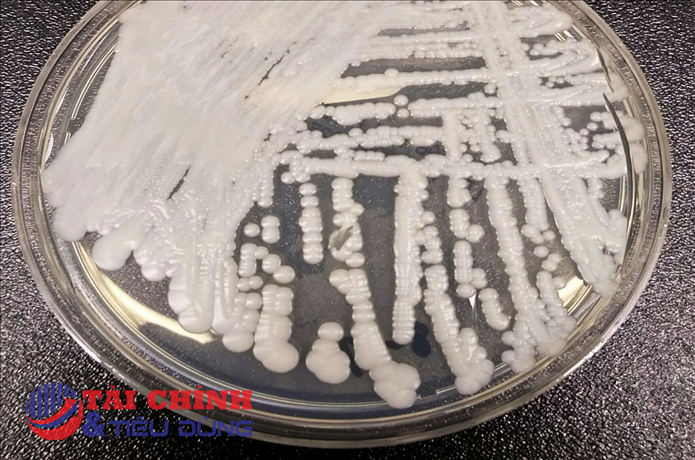
Xuất hiện loại nấm có thể gây chết người trú ngụ trong tai chó

Thương vụ Việt Nam tại Ấn Độ cho biết, Tổng cục Ngoại thương, cơ quan thuộc Bộ Công thương Ấn Độ, hôm 20/7 đã ra thông báo số 20/2023 về việc cấm xuất khẩu tất cả các loại gạo tẻ thường ((Phi Basmati).
Quyết định của cơ quan chức năng nước này về cấm xuất khẩu gạo tẻ thường có hiệu lực ngay lập tức.
Theo đó, chỉ một số trường hợp được tiếp tục xuất khẩu gồm: Lô hàng bắt đầu đưa lên tàu trước thời điểm thông báo.
Các lô hàng đã có hóa đơn vận tải đã được điền, con tàu đã cập cảng Ấn Độ và thứ tự bốc hàng lên tàu đã được cấp.
Lô hàng đã được chuyển cho Hải quan trước khi Thông báo và đã được đăng ký trên hệ thống hải quan điện tử hoặc lô hàng đã đưa vào kho hải quan để xuất khẩu trước thời điểm Thông báo. Thời điểm xuất khẩu các lô hàng này là đến 31/8/2023.
Lô hàng được xuất khẩu theo giấy phép của Chính phủ Ấn Độ tới các quốc gia nhằm đáp ứng nhu cầu An ninh lương thực và dựa trên đề nghị của Chính phủ nước đó.
Theo số liệu của Bộ Công Thương Ấn Độ, trong tháng 5/2023, Việt Nam nhập khẩu khối lượng gạo kỷ lục từ Ấn Độ, đạt khoảng 101 nghìn tấn, tăng 56,64% so với tháng 5 năm 2022, vươn lên đứng thứ 4 trong số các nước nhập khẩu gạo Ấn Độ tính về khối lượng. Tính trong 5 tháng đầu năm 2023, Việt Nam nhập khẩu 367,5 nghìn tấn gạo Ấn Độ, tăng 31,76% so với cùng kỳ, đứng thứ 8 trong số các nước nhập khẩu gạo Ấn Độ.
Các doanh nghiệp Việt Nam đang nhập khẩu gạo từ Ấn Độ cần liên hệ ngày với các đối tác xuất khẩu để kiểm tra tình trạng hàng hóa và đề nghị doanh nghiệp Ấn Độ liên hệ ngay với văn phòng Tổng cục Ngoại thương ở các khu vực để được hướng dẫn.
Lệnh dừng xuất khẩu gạo được Ấn Độ đưa ra trong bối cảnh giá gạo tại nước này đã tăng hơn 11,5% trong vòng 1 năm qua và 3% chỉ trong tháng vừa qua. Các diễn biến thời tiết không thuận trong vụ lúa xuân hè càng thúc đẩy Chính phủ Ấn Độ đi tới quyết định này.
Lượng mưa sụt giảm tại các bang nông nghiệp quan trọng như Bibar - giảm 40%, Odisha - giảm 15%, Jharkhand - giảm 44%; trong khi mưa lại gia tăng vượt mức thông thường tại một số bang nông nghiệp khác như Punjab - tăng 52% và Haryana - tăng 65%, đang tác động tới sản lượng và chất lượng của các mặt hàng lương thực, ngũ cốc. Lệnh dừng xuất khẩu được cho là nhằm thúc đẩy nguồn cung lương thực trong nước và giúp kiểm soát lạm phát.
Gạo là nguồn lương thực chính cho khoảng một nửa dân số thế giới, trong đó Châu Á tiêu thụ khoảng 90% nguồn cung toàn cầu. Giá gạo tiêu chuẩn đã tăng lên mức cao nhất trong hai năm qua do lo ngại về sự trở lại của hiện tượng El Nino có thể gây hại cho mùa màng.
Với vai trò là nước xuất khẩu gạo lớn nhất thế giới, chiếm tới 40% thị trường toàn cầu, quyết định cấm xuất khẩu gạo của Ấn Độ có thể gây ra xáo trộn lớn về giá trên thị trường quốc tế, đặc biệt trong bối cảnh chuỗi cung ứng lương thực vẫn đang chịu tác động bởi cuộc xung đột tại Ukraine.
Hồi tháng 9/2022, Ấn Độ đã áp dụng các biện pháp hạn chế xuất khẩu gạo như cấm xuất khẩu gạo tấm và áp thuế 20% đối với gạo trắng và gạo lứt sau xung đột Nga-Ukraine, khiến giá lương thực như lúa mì và ngô tăng vọt. Nước này cũng đã hạn chế xuất khẩu lúa mì và đường. Đến tháng 11/2022, Ấn Độ đã dỡ bỏ lệnh cấm này.
Ấn Độ hiện cung cấp gạo cho hơn 100 quốc gia, trong đó Benin, Trung Quốc, Senegal, Bờ Biển Ngà và Togo là những khách hàng lớn nhất.
Các nước nhập khẩu gạo như Indonesia, Trung Quốc và Philippines đang nhanh chóng tích trữ gạo trong năm nay. Hiện tượng El Nino đã quay trở lại vùng nhiệt đới Thái Bình Dương sau 7 năm, dự báo gây hạn hán cho nhiều vùng trồng lúa. Việc Ấn Độ ban hành lệnh cấm xuất khẩu gạo càng làm tăng lo ngại về nguồn cung.
Nguồn: thuongtruong.com.vn